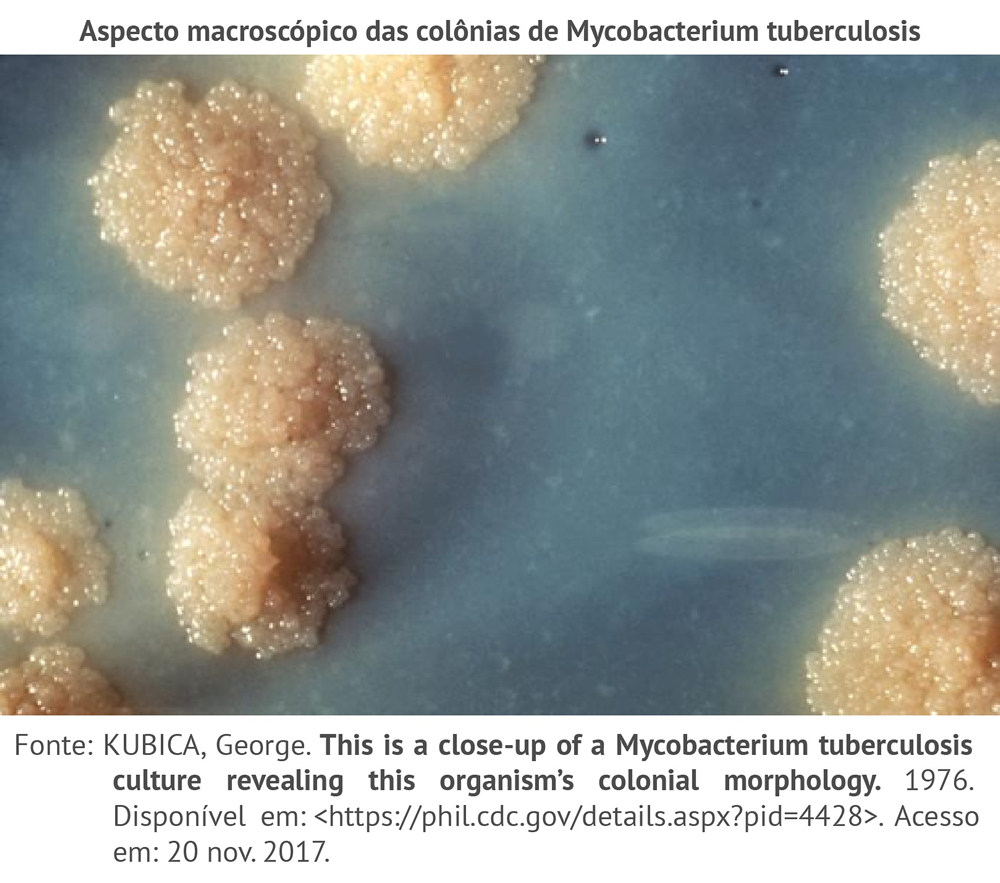

Se o exame de cultura permite detectar a presença do bacilo Mycobacterium tuberculosis, será somente esse o critério que devemos considerar na interpretação desse exame?
Diagnóstico laboratorial
Cultura para o isolamento de micobactérias
No Brasil, para o cultivo da micobactéria, utiliza-se dentre os meios sólidos, o de Lowenstein Jensen (LJ) e de Ogawa Kudouh (OK), à base de ovo. As culturas para isolamento de micobactérias devem permanecer incubadas até oito semanas antes de serem descartadas. O crescimento das colônias nos referidos meios de cultura se faz geralmente, nos seguintes tempos:
Lowenstein Jensen
3 a 4 semanas
Ogawa Kudouh
2 a 3 semanas
Dentre eles, o meio de cultura LJ é considerado padrão ouro para o diagnóstico definitivo de Mycobacterium tuberculosis.
Clique na figura ao lado e observe o aspecto rugoso e amarelado das colônias do bacilo, semelhantes a uma couve flor.
